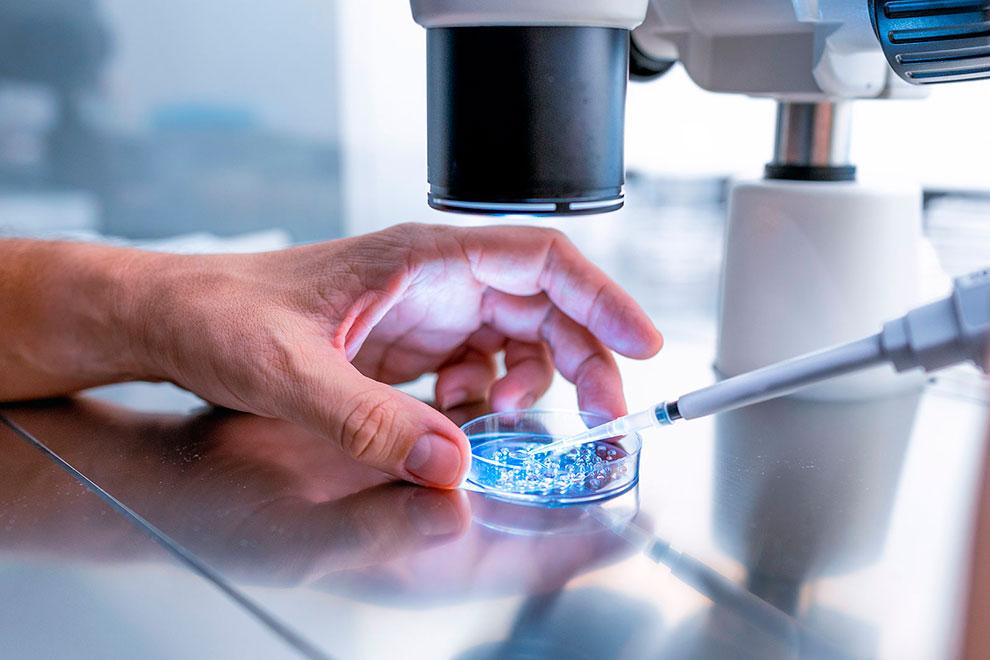
muestra en telescopio

La farmacogenética es una rama de la medicina personalizada que estudia cómo la genética de una persona puede influir en el efecto que pueden producir ciertos medicamentos. Esta disciplina permite adaptar los tratamientos farmacológicos a las particularidades genéticas de cada individuo, mejorando su eficacia y reduciendo el riesgo de efectos secundarios.
Análisis farmacogenético y el estudio del genoma
El estudio del genoma permite conocer muchas particularidades de cada individuo, desde la predisposición a ciertas enfermedades, la respuesta a agentes externos, la intolerancia algunos alimentos o la respuesta física al ejercicio, entre otros factores. Sin embargo, dentro de la medicina personalizada uno de los mayores hitos es el campo de la farmacogenética.
La farmacogenética es una rama de la medicina personalizada que estudia cómo la genética de una persona influye en su respuesta a los medicamentos. Esta disciplina permite adaptar los tratamientos farmacológicos a las particularidades genéticas de cada individuo, mejorando su eficacia y reduciendo el riesgo de efectos secundarios.
El análisis farmacogenético se realiza sobre 29 genes y su relación con más de 120 fármacos, lo que permite que el médico, en el momento de prescribir una medicación, pueda conocer cómo responde cada paciente a los medicamentos indicados.
Cuando tomamos un medicamento, nuestro cuerpo lo procesa a través de diversas rutas metabólicas, donde diferentes proteínas y, por tanto, genes específicos, juegan un papel crucial. Las variaciones genéticas pueden influir en la actividad de estas proteínas, modificando cómo metabolizamos y respondemos a los fármacos.
Cómo funciona la farmacogenética
Cuando tomamos un medicamento, nuestro cuerpo lo procesa a través de diversas rutas metabólicas, donde diferentes proteínas y, por tanto, genes específicos, juegan un papel crucial. Las variaciones genéticas pueden influir en la actividad de estas proteínas, modificando cómo metabolizamos y respondemos a los fármacos.
En base a estas variaciones, las personas nos podemos clasificar según los tipos de metabolizadores:
- Los metabolizadores lentos presentan una actividad metabólica baja o nula para ciertos medicamentos, lo que puede llevar a una acumulación tóxica del fármaco o a un fracaso terapéutico si el medicamento necesita ser activado para ejercer su efecto.
- Los metabolizadores normales generan una respuesta estándar a los medicamentos.
- Los metabolizadores rápidos metabolizan los medicamentos más rápidamente, lo que puede reducir la eficacia del tratamiento o, en algunos casos, provocar una activación excesiva del fármaco.
- Los metabolizadores ultrarrápidos presentan una actividad metabólica muy elevada, lo que puede incrementar significativamente el riesgo de toxicidad o reducir la eficacia del tratamiento.
Modelo de metabolización
No obstante, no todos los genes implicados en farmacogenética se clasifican según este modelo de metabolización. Existen otros mecanismos relevantes, como:
- La actividad reducida de transportadores o enzimas, como ocurre con el gen SLCO1B1 en el caso de las estatinas. En estas situaciones, el fármaco puede permanecer más tiempo del deseado en el organismo, aumentando el riesgo de toxicidad.
- También existen variantes genéticas asociadas a un mayor riesgo de hipersensibilidad, como HLA-B57:01* y el tratamiento con abacavir. En estos casos, la alteración genética no afecta al metabolismo del fármaco, sino que incrementa la probabilidad de reacciones adversas graves de tipo inmunológico, similares a una alergia, como el síndrome de Stevens-Johnson.
Aspectos claves en la farmacogenética
En este contexto, hay dos aspectos clave que ayudan a entender el valor de la farmacogenética en la práctica clínica:
- Uno es la especificidad de las rutas metabólicas: cada ruta metabólica afecta a grupos específicos de medicamentos. Además, una misma proteína puede inactivar un medicamento y activar otro, lo que hace necesario evaluar la respuesta de cada fármaco según la variante genética del individuo.
- El otro aspecto clave son las interacciones entre medicamentos. Los cambios en una ruta metabólica pueden afectar la acción de otros fármacos, lo que resulta especialmente relevante en pacientes que toman varios medicamentos, ya que puede complicar su manejo, sobre todo en tratamientos crónicos.
Ejemplos de farmacogenética en acción
- Gen CYP2D6 y la codeína: la codeína se transforma en morfina (el principio activo) a través de la enzima CYP2D6. Las personas que tienen metabolizadores ultrarrápidos producen morfina en exceso, aumentando el riesgo de toxicidad en el tratamiento y el de los efectos secundarios graves como problemas respiratorios. Por otro lado, los metabolizadores lentos no generan suficiente morfina, por lo que no aliviarían el dolor suficientemente. Por ello, la codeína no es recomendada para personas con estas variantes genéticas.
- Gen DPYD y las fluoropirimidinas: el gen DPYD participa en la metabolización de medicamentos como el 5-fluorouracilo (5-FU), utilizado en tratamientos contra el cáncer. Variantes del gen DPYD pueden convertir a una persona en un metabolizador intermedio o lento, aumentando el riesgo de toxicidad grave o incluso mortalidad si reciben la dosis estándar de 5-FU. Por lo tanto, es necesario ajustar la dosis o buscar tratamientos alternativos en función del genotipo del paciente.
Importancia y aplicación clínica
La implementación de la farmacogenética en la práctica médica permite a los profesionales de la salud prescribir medicamentos de manera más segura y eficaz, basándose en la información genética del paciente. Sociedades médicas, tanto el consorcio de implantación de farmacogenética clínica (CPIC), sociedades locales e incluso organismos gubernamentales han desarrollado recomendaciones clínicas específicas para el uso de ciertos fármacos según el genotipo del paciente, asegurando una mejor optimización del tratamiento.
En resumen, la farmacogenética representa un avance significativo hacia una medicina más personalizada, donde los tratamientos pueden ser adaptados a las características genéticas únicas de cada individuo, mejorando así los resultados terapéuticos y minimizando los riesgos de efectos adversos.